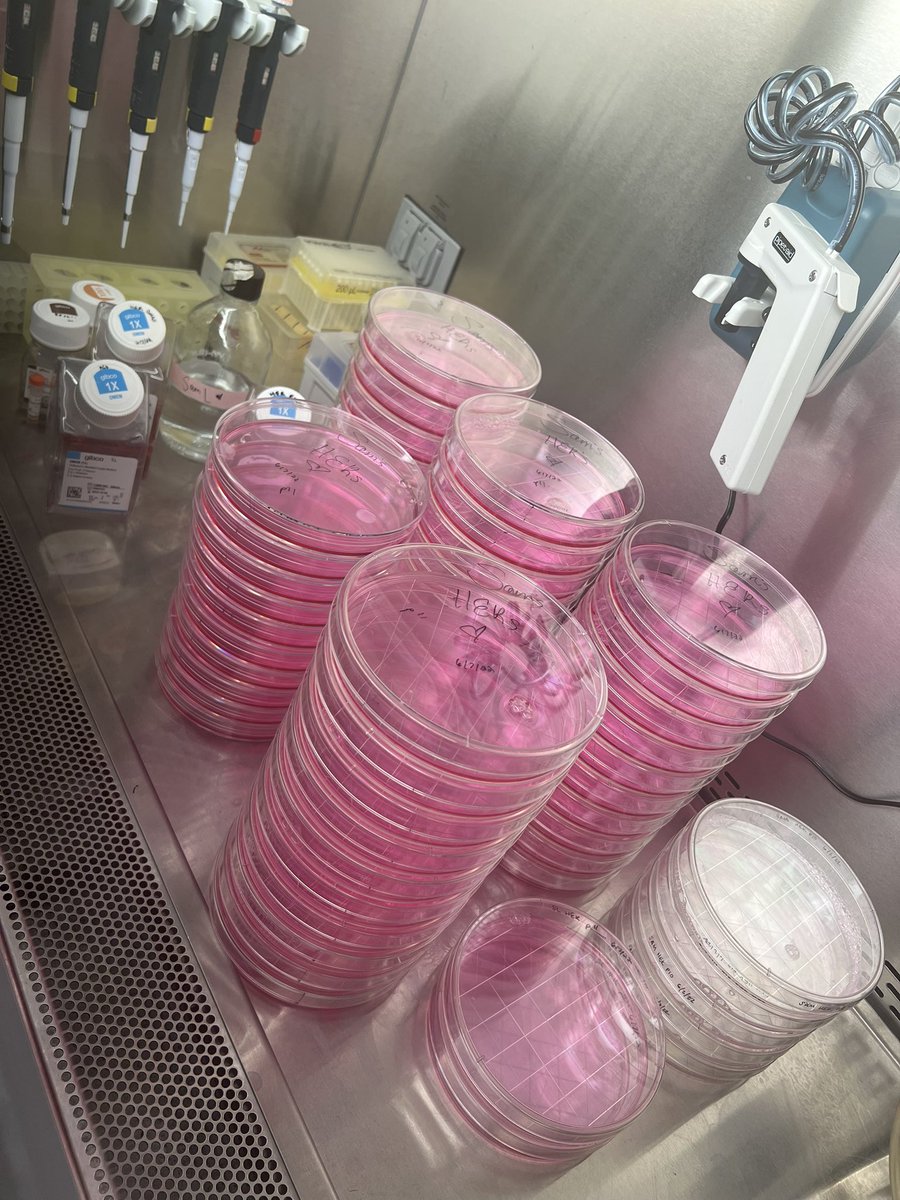

Ascano Lab
@ascanolab
Post-transcriptional gene regulation in innate immunity, RNA biochemistry, and cGAS-STING
ID: 915218764634959873
https://medschool.vanderbilt.edu/ascano-lab/ 03-10-2017 14:15:32
224 Tweet
421 Followers
192 Following


A 5.5 mile hike before presenting a poster at #RNA2022 tonight? When in Boulder- count me in!! Yelena Perevalova Ascano Lab The RNA Society


Come join us! Multiple funded openings in #RNABiology / #InnateImmunity / #viruses Ascano Lab Vanderbilt University, in #Nashville #DestinationBiochemistry Postdoc scholar awards available. medschool.vanderbilt.edu/biochemistry/d…… Just DM me or hunt me down at The RNA Society #RNA2022

Had such an invigorating time talking science for 2.5 hrs last night at #RNA22. The time flew by! Thanks to all who stopped by for the great discourse 🤗 The RNA Society Ascano Lab #RNA2022


Great talk by Kate Dicker from the Castello Lab on host RBPs that are encapsidated with the HIV genome! Unanticipated associations with interesting mechanisms that govern viral pathogenesis The RNA Society #RNA2022



Celebrating 1/2 of the Hodgescano Lab today! Congrats to The Hodges Lab and @TylerJohnHansen


Reason #1 (1/day for Dec) for #lifeinscience: Flexibility. Kimryn Rathmell and I had kids in grad school and post-doc. We set our own schedules in lab and that flexibility was key to a great family #WorkLifeBalance. Kids now 27 (lawyer) and 22 (grad student)

First story from our lab 🥳, out in Nature Communications today! Using direct mRNA sequencing to identify and study pseudouridine mods in human cells and find site with high occupancy. Congrats to Sepideh Tavakoli Caroline McCormick Wanunu Lab from Northeastern University Bioengineering nature.com/articles/s4146…

Welcome to the 28th Annual Meeting of the The RNA Society in beautiful Singapore! Just a friendly reminder that the official hashtag is #RNA23 thanks!





Awesome talk by Sam Lisy about her work on the antiviral RBP IFIT1 and the identification of its host-encoded capped RNA targets, using an elegantly simple addition to CLIP-seq approaches. Basic principles leading to discoveries. The RNA Society Vanderbilt Biochemistry Neelanjan Mukherjee


Winding down another great day at #RNA23 🇸🇬, with Sam Lisy and colleagues. Singapore slings! Sujatha Jagannathan @HoggLab Nick Guydosh The RNA Society


Awesome talk on small molecule targeting of disease relevant RNAs by Amanda Hargrove Amanda Hargrove #RNA23 The RNA Society

Winding down a whirlwind week in Singapore. We had the best time talking science and meeting new and old friends at #RNA23. Ascano Lab The RNA Society Vanderbilt Biochemistry


Congrats to newest Vanderbilt Biochemistry Asst Professor Sezen Meydan for receiving the 2023 RNA Society/CSHL Award for Research Excellence by an Underrepresented Scientist Vanderbilt School of Medicine Basic Sciences


Flew halfway around the world and bumped into Prince’s hot chicken royalty, fellow UIUC alum, and RNA classic biochem junkie. Best wishes to Lauren Hagler, PhD as you prepare for the next step in your career #HannaGrayFellows Vanderbilt School of Medicine Basic Sciences Vanderbilt Biochemistry UniversityofIllinois HHMI